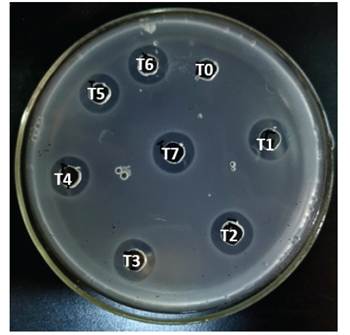
Antimicrobial activity against Listeria strains of silage inoculated during the fermentation process.

Artículos
Silage production from agro-industrial by-products fermented with lactic acid bacteria isolated from the marine environment
Producción de ensilados a partir de subproductos agroindustriales fermentados con bacterias ácido lácticas aisladas del ambiente marino
Silage production from agro-industrial by-products fermented with lactic acid bacteria isolated from the marine environment
Revista Facultad Nacional de Agronomía Medellín, vol. 78, no. 2, pp. 11103-11116, 2025
Facultad de Ciencias Agrarias - Universidad Nacional de Colombia
Received: 16 February 2025
Accepted: 06 April 2025
ABSTRACT: The increase in demand for food induces food industry activity, generating waste that could be used as silage for animal feed through biological fermentation. This study evaluated the evolution of physicochemical parameters of biological silage (BS) using by-products from food industries through a seven-day fermentation process. The silages of fish muscle and whey (F+W), and fish muscle and residual brewer's yeast (F+RBY) were inoculated with lactic acid bacteria (LAB), previously selected. The drop in pH, water-soluble protein fraction, trichloroacetic acid-soluble protein fraction and antimicrobial activity were registered in both matrices. The total protein content, antioxidant activity, trypsin inhibition, phytase activity, free phosphorus determination and Ca2+, Fe2+, Mg2+ concentrations were registered in F+RBY. A pH drop was registered in both matrices (F+RBY=5.4; F+W=5.47). In both cases, the soluble peptide concentration in water and trichloroacetic acid increased during the fermentation process, and the antimicrobial activity was registered from day one of the fermentation process. Complimentary assays were carried out only with F+RBY. An increase in the antioxidant capacity of BS was detected with DPPH and CUPRAC methods. The total protein content displays no significant differences during assays. The phosphate concentration remained stable, with values of 2.06 and 1.72 mg g-1 of silage for the control and BS, respectively. Low phytase activity was registered through the fermentation process, and the concentration of divalent cations remained stable during the fermentation process. Trypsin inhibitory activity was not registered. The use of matrices from discards of the feed industry, fermented with LAB, used for animal feed suggests a potential application for the revaluation of by-products.
Keywords: Food industry wastes, Lactic fermentation, Residual brewer's yeast, Whey.
RESUMEN: El aumento en la demanda de alimentos induce la actividad industrial alimentaria, generando residuos que podrían ser utilizados como ensilados para la alimentación animal mediante fermentación biológica. Este estudio evaluó la evolución de parámetros fisicoquímicos de ensilados biológicos (EB) utilizando subproductos de las industrias alimentarias, mediante un proceso de fermentación de siete días. Ensilados de músculo de pescado y lactosuero (P+LS) y, músculo de pescado y residuo de levadura cervecera (P+RLC) fueron inoculados con bacterias ácido lácticas (BAL), previamente seleccionadas. Se registró el descenso del pH, la fracción proteica soluble en agua, en ácido tricloroacético y la actividad antimicrobiana. Se registró en P+RLC el contenido total de proteínas, la actividad antioxidante, inhibición de tripsina, actividad fitasa, determinación de fósforo libre y las concentraciones de Ca2+, Fe2+, Mg2+. Se registró una caída del pH en ambas matrices (P+RLC=5,4; P+LS=5,47). En ambos casos, la concentración de péptidos solubles en agua y ácido tricloroacético aumentó durante el proceso de fermentación, y la actividad antimicrobiana se registró desde el primer día del proceso de fermentación. En P+RLC, se detectó un aumento en la capacidad antioxidante del EB con los métodos DPPH y CUPRAC. El contenido total de proteínas no exhibió diferencias significativas. La concentración de fosfato se mantuvo estable, con valores de 2,06 y 1,72 mg g-1 de ensilaje para el control y EB, respectivamente. El proceso de fermentación registró una baja actividad fitásica y la concentración de cationes divalentes se mantuvo estable. No se registró actividad inhibidora de tripsina. El uso de matrices procedentes de descartes de la industria alimentaria, fermentadas con BAL, utilizadas para la alimentación animal sugiere una potencial aplicación para la revalorización de subproductos.
Palabras clave: Residuos de la industria alimentaria, Fermentaciones lácticas, Residuo de levadura cervecera, Suero.
Currently, there is a growing demand for food due to global population growth. Consequently, the food industry has increased production, generating waste during the elaboration process or after sales. The world's production of aquatic animals by capture fisheries is estimated at 90 million tons. Argentina, which has a vast coastal region, is among the leading producers of capture fisheries, with 0.82 million tons of live weight (FAO 2022a). Some of the waste produced during processing is used in ornamental fish feed, while another large amount is reduced into fish oil and fishmeal. However, this processing would not be economically sustainable in small-scale processing, such as the distribution of whole fish for sale (Toppe et al. 2018).
World dairy production in 2022 hovered around 930 million tons, an increase derived mainly from volumetric expansions in Asia, Central America, and the Caribbean. In South America, milk production was 65.6 million tons (FAO 2022b). In Argentina, according to the Observatory of the Argentine Dairy Chain (OCLA), the volume produced was 11,557.4 million liters, equivalent to 11,904.12 million tons.
In addition to its direct consumption, the fate of milk is derivative production, among which cheese stands out. The significant by-product produced is whey, whereas its discard tends to damage the environment due to the high amount of organic matter (Sakr et al. 2021).
Beer is the most consumed alcoholic beverage worldwide, with approximately 177.50 billion liters in 2020 (Santacruz et al. 2023). The high production worldwide results in significant amounts of waste, estimating that for every 100 liters of beer brewed, between 14-20 kg of grain, 0.2-0.4 liters of hot trub, and 1.5-3 kg of yeast are produced. Considering only the three largest producers (China, USA, and Brazil), world beer production reaches almost 84 billion liters annually, making approximately 143 million kg of grains, 2.5 million kg of residual brewing yeast, and 19 million kg of residual yeast (Mathias et al. 2016).
The wastes mentioned above have much organic matter that can be used for animal and fish nutrition. One method for using by-products is through the production of silage by the use of acid preservation (acid silage) or anaerobic microbial fermentation (microbial silage), thus reducing the waste produced and the production costs in aquaculture or livestock farming. The latter is of greater interest because they are relatively cheaper and easier to make, taking advantage of the metabolic characteristics of the bacteria used during the fermentation process, thus obtaining a nutritious, stable product with antimicrobial capacity (Peña et al. 2020). Furthermore, biological silage is advantageous because it enhances the availability of nutrients and minerals generated by the fermentation of processed wastes (Marti-Quijal et al. 2020).
Lactic acid bacteria (LAB) have gained relevance in recent years due to their use in elaborating functional foods. Their proteolytic activity, antimicrobial agents' synthesis, and antioxidant capacity result in a product with better nutritional properties than raw food or chemical processing. LAB is a group of microorganisms located in the Clostridia branch of gram-positive bacteria, which includes non-spore-forming cocci, coccobacilli, anaerobes, or aerotolerant, with a DNA base composition of less than 50% in G+C. LAB have a proteolytic system composed of proteinases, peptidases, and specific transport proteins, allowing them to degrade and consume high molecular weight proteins in the medium. On the other hand, they can ferment sugars into lactic acid, thus obtaining the necessary energy for their development in anaerobic conditions (Kieliszek et al. 2021).
The acid environment produced in biological silages by LAB, together with the ability to synthesize compounds with antimicrobial activity, prevents or inhibits the development of possible pathogenic and food spoilage organisms and contributes to preserving the nutritional value and energy content through the metabolic capacity of the bacteria (Baños et al. 2019).
Moreover, phosphorus (P) is a crucial mineral to be considered in animal feed because it improves growth, development, and firmness in the muscle of animals raised in the fields of livestock and aquaculture (Wen et al. 2015). In modern livestock production, cereal grains and oilseeds have their P source as phytates, finding about 70% of the phosphorus in barley like this compound. The degrading inefficiency of phytate is a problem in P that may be related to some organisms that do not possess phytase, a digestive enzyme necessary to hydrolyze the phytate molecule. Some microorganisms, such as LAB and yeasts, harbor this enzyme and metabolize phytic acid, leaving P bioavailable in phosphate groups. The achievement of the latter points depends mainly on selecting adequate strains that could be used as inoculums during the fermentation process (Toppe et al. 2018).
The concept of circular economy is currently taking resonance through a change in the traditional "take-make-waste" model. Using industrial by-products in new productive chains and reducing untreated waste is a new trend toward cleaner food production through a "cascading" use (Cerdá and Khalilova 2016).
This study evaluated the evolution of physicochemical parameters of biological silage using by-products from the brewing, dairy, and fishing industries through a seven-day process. The silage was inoculated with LAB previously selected based on their technological properties.
MATERIALS AND METHODS
Selection of lactic acid bacteria
Strains from marine organisms belonging to the Bacterial Biotechnology laboratory (Facultad de Ciencias Naturales y Ciencias de la Salud, Universidad Nacional de la Patagonia San Juan Bosco, Trelew), were selected based on their biotechnological potential. The Lactococcus lactis subsp. lactis Tw34 strain was selected based on its antimicrobial and phytase activity (Marguet et al. 2013). Enterococcus mundtii Tw278 strain was selected based on its antimicrobial and antioxidant capacity (Sosa et al. 2022; Sosa et al. 2023), and Lactobacillus sp. Tw93 strain was selected based on its proteolytic activity. All strains were replicated in Man Rogosa Sharpe (MRS) agar (Biokar, France) for 24 h at the optimum temperature.
Silage preparation and fermentation process
The silage was prepared based on combinations of waste from the fishing, dairy, and brewing industries. Common hake (Merluccius hubbsi) muscle discards were collected from a local fish market in Rawson Harbor, province of Chubut (longitude -65.0532532, latitude -43.3325653). Lactic whey was obtained from an artisanal producer of Trelew, province of Chubut (longitude -65.30505, latitude -43.3325653) after cheese-making. Residual brewing yeast was provided by Cerveceria Rijavec, located in Rawson, province of Chubut (longitude -65.1078894 latitude -43.3022935. The substrates for biological silage were carried out by mixing 70% fish homogenate with 28% lactic whey or residual brewing yeast; after homogenization, 1% potassium sorbate (Productos Químicos, Argentina) and 1% edible yeast (Titan, France) were added to both mixtures (Figure 1). The selected strains were incubated overnight in MRS broth at the optimum temperature. Furthermore, the cultures were centrifuged at 4,000 g for 15 min, and the supernatants were discarded. After that, pellets were washed twice and resuspended in sterile distilled water.

Figure 1
Silage preparation and fermentation process treatments.
The biological silage (BS) was subjected to a fermentation process for 7 days at 18 °C. Inoculation was carried out with 1% of the resuspended pellet of each selected strain. Silage previously treated with lactic acid (Fluka - Switzerland) was prepared as a control until the pH reached 4.7. Samples of 1 g of silage were collected in a Falcon tube and 0.5 g in an Eppendorf tube every 24 h until the end of the experiment. The tests were carried out in triplicate, and the samples obtained were stored at -30 °C until processing.
pH determination
During the fermentation process, the pH of the silage was measured daily with an Orion Model 410A pH- meter with an Orion 8135BN solids electrode.
Determination of protein fraction
The protein fractions were determined following the methodology described by Marguet et al. (2017). Briefly, 10 mL of distilled water was added to 1 g of the sample and homogenized with a vortex mixer. After storing at 4 °C for 24 h, the mixtures were centrifuged at 2,000 g for 15 min. The O-phthalaldehyde technique was used to evaluate the concentration of water-soluble peptides in the supernatant (Church et al. 1983).
The soluble protein fraction in trichloroacetic acid was determined by mixing 500 µL of the processed sample of the water-soluble fraction with 500 µL of trichloroacetic acid (TCA) and subjected to vigorous agitation for 1 min, and was incubated for 10 min. The sample was centrifuged at 12,000 g for 2 min, and the concentration of soluble peptides in the supernatant was determined with the O-phthalaldehyde assay. Absorbance values of water-soluble and TCA-soluble peptides were measured at 590 nm in a UV/vis Jenway 6405 spectrophotometer. The results were expressed in mg equivalents of leucine per 100 grams of silage.
Evaluation of antimicrobial activity during fermentation process
A 500-mg sample was resuspended with 500 µL of sterile distilled water and vigorously mixed with a vortex. After centrifugation at 12,000 g for 2 min, 50 µL of supernatants was placed in wells of 6 mm in diameter cut in Brain Heart Infusion (Biokar, France) plates seeded with a stationary phase cell suspension of Listeria innocua ATCC 33090, L. innocua Tw67 and L. monocytogenes Scott A, used as indicator microorganisms. After incubation for 24 h at 37 °C, a clear zone around the wells was considered inhibitory activity.
Total protein determination
The crude protein content was determined at the beginning and the end of the assay of control and BS using Kjeldahl digestion (N factor=6.25) (Method 976.05) (AOAC 1990). It was also determined the moisture content of control and biological silage by drying the samples in an oven at 95 °C until a constant weight was achieved (Method 934.01) (AOAC 1990).
Determination of antioxidant capacity during the fermentation process
Antioxidant activity by reduction of 2,2 diphenyl-1-picryhydrazyl (DPPH): The DPPH assay was carried out following the recommendations of Zhang et al. (2013). In brief, 1 mL of DPPH reagent was inoculated with 100 µL of the sample (1 g of silage sample homogenized in 10 mL of distilled water) and incubated in the dark for 30 min. Afterward, the absorbance was measured at 517 nm. The antioxidant capacity results were expressed as mmol ascorbic acid equivalents per gram of silage.
Cupric Ion Reducing Antioxidant Capacity (CUPRAC): The CUPRAC assay was performed following the recommendations of Apak et al. (2004). The reaction reagent was prepared with 1 mL neocuproine (1 mg mL-1 in ethanol), 1.5 mL of sodium acetate buffer (0.05 M, pH=6.0), and 0.5 mL of CuCl2 (0.01 M). The samples were prepared as explained in "Determination of protein fraction" section. After centrifugation, 100 µL were inoculated in 900 µL of CUPRAC reagent and incubated at 37 °C for 1 h. The absorbance was read at 450 nm, and the results obtained were expressed as mmol ascorbic acid equivalents per gram of silage.
Determination of free phosphorus
The concentration of free phosphorus in the BS was determined as proposed by Marguet et al. (2017). A phosphate reagent containing 0.6 M H2SO4, 2% ascorbic acid, and 0.5% ammonium molybdate was prepared. Initially, 100 µL of the sample was seeded in 900 µL of reagent and incubated for 30 min at room temperature. Subsequently, the absorbance reading was performed at 820 nm. The results were compared with a calibration curve of a KH2PO4 solution.
Determination of phytase activity
The determination of phytase activity was carried out following the method proposed by Marguet et al. (2013). In brief, 100 µL of the sample was seeded in 900 µL of a reaction mixture of 1 mg mL-1 sodium phytate dissolved in 0.1 M acetate buffer pH=5.5 and incubated at 35 °C for 30 min. Subsequently, the reaction was stopped by adding 1 mL of trichloroacetic acid (10% v/v). Afterward, 100 µL were inoculated in 900 µL of the previously used phosphate reagent and incubated at room temperature for 1 h. Finally, the absorbance at 820 nm was measured. The phytase enzymatic unit (EU) was defined as the enzyme required to liberate 1 µmol of phosphate per minute from sodium phytate under stated pH and temperature conditions.
Trypsin inhibitory activity determination
The substrate was composed of azocasein (10 mg mL-1 in TRIS buffer, 0.1 M and pH=8.5) treated with trypsin (0.5 mg mL-1). Then, the mixture was divided into aliquots of 1 mL and 100 µL of the silage sample was inoculated. After incubation at 37 °C, the reaction was stopped by adding 100 µL of 24% TCA and centrifuged at 13,000 g for 2 min. The obtained supernatant was treated with 600 µL of 0.5 M NaOH. The absorbance reading was performed at 450 nm. The trypsin inhibitory activity was calculated following Liu and Markakis (1989)Equation (1), as follows:

Where Ar is the absorbance of the reagents and As is the absorbance of the silage sample.
Determination of divalent cations
For sample preparation, a 500-mg sample was resuspended with 500 µL of sterile distilled water and vigorously mixed with a vortex. The determination of Calcium (Ca2+), Iron (Fe2+), and Magnesium (Mg2+) were carried out using the following techniques.
Determination of Ca2+
Calcium determination was carried out as Ray and Chauhan (1967) proposed. Briefly, 50 µL of control and BS were mixed with 1.0 mL of O-Cresolphthalein and 8-hydroxyquinoline and 1.0 mL of aminomethyl propanol and incubated at 25 °C for 5 min. Finally, the absorbance was measured at 570 nm. A standard curve of CaCl2 was used to determine calcium concentration.
Determination of Fe2+
Iron determination was determined as proposed by Jeitner (2014). Briefly, 300 µL of control and BS samples were mixed with 20 µL of ascorbic acid 1 M, and 80 µL of 50 mg ferrozine per milliliter potassium acetate buffer (500 mM). The reaction was carried out at 37 °C for 135 min. Finally, the absorbance was measured at 562 nm, and the result was compared with an absorbance standard curve using known concentrations of FeCl3.
Determination of Mg2+
In brief, 10 µL of control and BS were mixed with 1.0 mL of a reaction mixture of xylidyl blue 0.1 mM and EGTA 0.04 mM on Tris buffer (0.22 M, pH=11.3), and incubated for 5 min at 25 °C. The absorbance was measured at 510 nm and the results were compared with a curve using known concentrations of MgO (Kafesa et al. 2021).
Statistical analysis
All assays were performed independently and in triplicate. The data were subjected to an analysis of variance (ANOVA), and the significant differences between the means were determined using Tukey's test (P<0.05). The statistical software Statgraphics Centurion XV (15.1.02, Statsoft, The Plains, Virginia - USA) was used.
RESULTS AND DISCUSSION
Drop in pH during the fermentation process
Figure 2 shows the evaluation of pH as a function of time for all residue combinations. In all cases, the combinations of residues from the dairy and brewing industry with by-products from the fishing industry allowed the development of LAB, observing a reduction in pH during the experiment. A final pH value of 5.4 was obtained with fish muscle and residual brewing yeast and 5.47 in the combination of fish muscle and whey.

Figure 2
pH drop during fermentation process. The values obtained correspond to the mean and standard deviation in triplicate. A. Fish muscle + whey and B. Fish muscle + residual brewing yeast.
Lactic acid generated by the LAB inoculated at the beginning of fermentation produces pH drop values. Similar results of pH were obtained by Fernández et al. (2015), who made silages with hake waste supplemented with yogurt as a fermentative agent in different proportions, reaching a stabilization between 5.1 and 5.3. On the other hand, Castillo et al. (2019) obtained a drop in pH between 4.2 and 4.7 after 30 days of fermentation, and Peña et al. (2020) obtained at the end of the experiment a pH of 4.5. In both cases, these biological silages were composed of fisheries residues, supplemented with 25% molasses.
Differences in the pH values obtained may be due to differences in the concentration of fermentable sugars. For the production of the fermentation matrix, 28% of the residual brewing yeast added corresponds to 0.52% of reducing sugars, according to the composition of sugar previously determined, and the 28% of the whey used is equivalent to 1.4% of lactose according to the concentration of fermentable sugars present in this waste, according to Ramirez (2012). Differences are observed in terms of the origin and concentration of sugars used in other fermentation matrices, such as the example of Raeesi et al. (2021), who supplemented the silage of fish residues with 15% (w/w) beet molasses. These differences result in a higher concentration of fermentable sugars for the development of bacterial inoculum and the production of lactic acid, producing a more significant decrease in pH values.
Another reason may be related to the fermentation temperature. In this study, the fermentation was carried out at 18 °C, taking into account the possibility of productive scale-up, where high temperatures translate into an increase in production costs, and a decrease in the probability of contamination. In another research, the temperatures of the fermentation processes were developed within a range between 24-30 °C (Peña et al. 2020; Raeesi et al. 2021), close to the optimal temperature for growth and development of the LAB.
During the growth and development of LAB, different metabolites are produced, including lactic acid, which plays a fundamental role in the fermentation matrices, influencing nutritional and sensory properties (such as texture and aroma). In addition, they exert a preservative effect on the products, improving their safety and shelf life by inhibiting the growth of undesirable microorganisms without favoring the development of antimicrobial resistance (Cortés et al. 2024).
Determination of protein fractions
Water-soluble protein fraction (WSP)
In Figure 3, an increase during the fermentation process of the peptides soluble in water can be observed compared to the control. Differences observed in the results depend on adding whey or residual brewing yeast, the latter exhibiting a higher concentration value, possibly due to the contribution of high molecular weight proteins from the residual brewing yeast (Mathias et al. 2014), which could be a substrate of proteolytic enzymes. The increase in the concentration of soluble peptides in water is mainly related to proteases from fish tissue, which exhibit their activity at acidic pH, as is the case with cathepsins. These proteolytic enzymes are located in the lysosomes of fish muscle and, through tissue disruption, can be released and produce protein lysis (Yoshida et al. 2015). During the silage process, these proteases are activated, improving the digestibility of proteins in fish muscle, such as actin, tropomyosin, α-actinin, and myosin, among others (Cortés et al. 2024). The peptides determined in the soluble fraction correspond to medium-large peptides. Additionally, this proteolytic activity was complemented with LAB proteases. These results were similar to those obtained by Marguet et al. (2017), who exhibited an increase in the concentration of soluble peptides during the fermentation process, with a maximum between 1,189-1,244 mg eq. of leucine per 100 g of silage.

Figure 3
Concentration of water-soluble peptides during the fermentation process. The values obtained correspond to the mean and standard deviation in triplicate. A. Fish muscle + whey and B. Fish muscle + residual brewing yeast.
Trichloroacetic acid soluble protein fraction (TSP)
Figure 4 shows the results obtained for the different combinations tested. An increase in the concentration of soluble peptides in TCA was observed during the fermentation process compared to that obtained in the control. Differences were observed in the concentration values obtained from the addition of whey and residual brewing yeast, with the brewing residue showing the highest concentrations. Peptides soluble in TCA are characterized by their small size, which may reflect the activity of the proteolytic system of the LAB inoculated at the start of the fermentation process. Similar concentrations of soluble peptides were observed when compared to the results of the water-soluble fraction. This suggests a synergistic effect between fish muscle proteases and microbial proteases, which reduced the size of the peptides in the silage, resulting in small peptides as the final product. The values obtained in this study are higher than those obtained by Marguet et al. (2017), who made silage with residues of hake and barley grains as a carbon source, supplemented with Lactococcus lactis subsp. lactis Tw34, obtaining values of soluble peptides in TCA between 771 and 840 mg of leucine per 100 grams of silage. LAB strains possess a proteolytic system composed of proteinases, peptidases, and specific transport proteins, classified as exopeptidases or endopeptidases that process proteins and peptides into free amino acids, di, tri, and oligopeptides (Kieliszek et al. 2021). The increase in small peptide concentration improves digestibility and palatability, which is related to a higher efficiency of animal food intake and a lower amount of environmental waste (Marguet et al. 2017).

Figure 4
Concentration of soluble peptides in trichloroacetic acid during the fermentation process. The values obtained correspond to the mean and standard deviation in triplicate. A. Fish muscle + whey; B. Fish muscle + residual brewing yeast.
Evaluation of antimicrobial activity during the fermentation process
In Figure 5, the inhibition halos of the growth of Listeria strains can be observed due to the antimicrobial activity of the silages. In the control, no antagonist activity can be observed throughout the process. Meanwhile, in the inoculated silages, supplemented with residual brewing yeast or whey, the antimicrobial activity against the strains L. innocua ATCC 33090, L. innocua Tw67, and L. monocytogenes Scott A was registered after 24 h of incubation, and was maintained throughout the test. These results contrast with those obtained by Ozyurt et al. (2017), who did not observe inhibitory activity in spray-dried fish silage against gram-positive and negative bacteria tested.
Figure 5
Antimicrobial activity against Listeria strains of silage inoculated during the fermentation process.
One of the LAB's selection criteria for silage production was antimicrobial activity, observing its effective development in the matrix of fish and waste. The antimicrobial capacity could be associated with diverse membrane compounds or the production of bacteriocins, ribosomally synthesized peptides active against phylogenetically related microorganisms (Baños et al. 2019). In particular, the production levels of bacteriocins produced by LAB depend on the strain, medium compounds, and physical parameters. In previous research, Sosa et al. (2022) demonstrated that the strain E. mundtii Tw278 reached the highest inhibitory activity when a mixture of cheese whey and hot tub was used for cell growth. The production of metabolites with antimicrobial activity is a characteristic of interest for selecting potentially usable microorganisms in fermentative processes, since they prevent the appearance of pathogenic or food spoilage bacteria, avoiding chemical preservatives.
According to the results obtained, the silage model composed of fish muscle and residual brewing yeast from the brewing industry was considered for the following tests.
Determination of total protein
The total protein content for the control was 15.81% at the start of fermentation and 15.23% at the end of fermentation, with a moisture content of 81.5 and 81.26%, respectively. In the case of BS, 16.03% total protein was recorded at the beginning of fermentation and 15.08% on the seventh day of the trial, with a moisture content of 81.57 and 80.38%, respectively. These results were comparable with those of Leonarduzzi et al. (2014), who obtained an average total protein content of 15.84% and a moisture content of 79.25% when performing the proximal analysis on muscle samples of M. hubbsi.
Determination of antioxidant capacity
The results of antioxidant capacity obtained by DPPH and CUPRAC methods are shown in Table 1. The antioxidant capacity of the DPPH method is observed through the interaction of free radicals with proton-donating antioxidant compounds, causing a decrease in absorbance compared with the control. The CUPRAC method is based on measuring the reducing power of antioxidant compounds to convert Cu2+ ions to Cu+, being a variation of the FRAP assay, where the reduction of the Fe+3 ion to Fe2+ is evaluated (Shahidi and Zhong 2015). During the fermentation process, the antioxidant capacity of the fermented silage with LAB remains constant. Significant differences between control and inoculated treatments were determined (P<0.05).

The results of DPPH are comparable with those obtained by Chen et al. (2021), where it is observed that, during the LAB fermentation process, there is an increase in the antioxidant capacity. Similar results were obtained by Yang et al. (2019), who observed an increase in the antioxidant capacity in fermented soybeans with Bacillus amyloliquefaciens SWJS22 60 h after fermentation.
Similar behavior was observed in Chen et al. (2018), where a fluctuation in the antioxidant capacity was observed in Lactobacillus acidophilus and L. plantarum strains during the 48 h fermentations in papaya juices. On the other hand, Jin et al. (2018), who tested six probiotic strains in mango liquid sludge, obtained values between 14-18 mM Trolox equivalents L-1 after 48 h of fermentation. These results highlight the development of antioxidant capacity in different by-products. However, it is difficult to compare the results of this study due to the differences between the units used for each experiment's results.
In both cases, the antioxidant capacity, expressed in ascorbic acid equivalents per g of silage, displays differences between the control and inoculated silage, the latter being higher. The results obtained from the antioxidant capacity of the control may be due to the bioactive compounds of the hydrolysate (Martínez 2011), and the existing difference with the samples of the inoculated silage may be due to both the contribution of compounds with antioxidant capacity present on the LAB strains (Sosa et al. 2023), as well as also the increase in the degree of hydrolysis by microorganisms to the silage matrix.
Bhagwat and Annapure (2019) suggest different methods to assess antioxidant capacity due to microorganisms' different radical scavenging systems. The presence of compounds with antioxidant capacity in food attracts the industry since artificial antioxidants usually used to prevent oxidative deterioration are avoided (Martínez 2011), and it must be considered that the biosynthesis of EPSs by LAB and the increase of amino acids during the fermentation process contribute to the antioxidant activity of the silage (Sharma et al. 2024).
Phytase activity and determination of free phosphorus
At the beginning of the experience, both control and inoculated mixtures exhibited a low enzymatic activity (0.06 and 0.09 EU g-1 of silage). Phytase activity in the control remained stable during the 7 days of the process. The inoculated silage showed a slight increase in activity on day 3 (0.11 EU g-1 of silage) due to the contribution of phytase of LAB; however, at the end of the process, values between control and inoculated silage were comparable (0.06 and 0.08 EU g-1 of silage, respectively). Phytase activity involves the hydrolysis of phytic acid and the release of phosphorus and essential minerals (Zn2+, Fe2+, Ca2+, Mg2+) (Belda 2022).
Despite cereals exhibiting phytase activity, the results are insufficient to improve the phosphorus and mineral bioavailability. Adding exogenous phytase or including high phytase active LAB or yeast to food processing can be overcome this drawback. Previous studies demonstrated that the selection and inclusion of LAB with high phytase activity degrades phytate efficiently and increases the free phosphorus concentration when whole grains are used in animal feed silage (Marguet et al. 2013). In the same direction, several attempts have been made to select phytase-active yeasts for grain-based food and beer elaboration (Nuobariene et al. 2011).
In this study, the addition of residual brewing yeast to fish muscle results in a high concentration of free phosphorus in the control and inoculated mixture (approximately 1.89 and 1.72 mg of phosphate g-1 of silage, respectively). Both concentrations remained stable until the end of the experience, displaying values of 2.06 mg phosphate per gram of sample and 1.77 mg of phosphate per gram of silage for the control and inoculated mixture, respectively.
The high amount of free phosphate on the control and inoculated matrices is related to the use of a residue resulting from the previous fermentation of barley grains with Saccharomyces cerevisiae for beer production (Nuobariene et al. 2011). The yeast displays a high phytase activity that hydrolyzes the phytic acid and derivatives present in the whole grain and releases free phosphates. The low increase of the inducible phytase of LAB during the fermentation suggests that the yeast's enzymatic activity during the beer production process hydrolyzed most of the phytic acid.
Phosphorus is essential in animal feed; however, when wholegrain products or derivatives are included, those metabolites that can inhibit or diminish intestinal absorption should be considered. Phytic acid is the principal storage molecule for phosphorus and acts as a strong chelator of cations (Zn2+, Fe2+, Ca2+, Mg2+); these forms of phytate result unavailable for absorption in the intestinal tract. In order to avoid these adverse effects, degradation of phytates by enzymatic activity is needed (Nuobariene et al. 2011).
Determination of divalent cations
The results of the divalent cations are presented in Table 2.

There were no significant differences (P>0.05) between control and BS during fermentation in the Ca2+, Mg2+, and Fe2+ concentrations. According to the absence of enzymatic induction of phytase activity, and the concentration of phosphorus obtained in this study demonstrated that most of the phytic acid was degraded during the brewing process. Moreover, the stability of divalent cations detected during the experience confirmed that they were not in chelated form with phytic acid. According to Samtiya et al. (2020), eliminating this compound increases the availability of minerals, allowing silages to be considered potential raw materials for developing diets for animal feed.
Trypsin inhibitory activity determination
This study assayed trypsin inhibitory activity because it is one of the most used techniques to determine an anti-nutritional parameter. The results showed that at the beginning of the experiment, the control and the BS displayed low inhibitory activity and remained without significant changes throughout the 7 days of incubation.
Besides phytic acid, several antinutritional compounds, such as glucosinolates, tannins, and protein inhibitors, are known to reduce the absorption of nutrients, including vitamins, minerals, and proteins, and inhibit proteolytic enzyme activity. Trypsin inhibitors in diets can reduce protein digestion and, subsequently, the bioavailability of amino acids, leading to a decrease in the growth rate (Samtiya et al. 2020). Several processing techniques and methods, such as germination, fermentation, autoclaving, soaking, etc., are used to reduce the anti-nutrient content of foods (Liu 2021). In this case, germination and heating eliminated most of the phytic acid. The other potential trypsin inhibitors, such as glucosinolates, polyphenols, and tannins, are eliminated during fermentation due to the enzymatic activity of LAB (Parada et al. 2023). Glucosinolates are effectively transformed into nitriles by myrosinase activity (Hsieh et al. 2024), and tannins are degraded to simpler compounds, such as gallic acid, by tannase activity (Parada et al. 2023). Phenolic compounds are transformed by LAB by esterase, reductase, and decarboxylase activity (Gaur and Gänzle 2023). These enzymatic activities during fermentation reduce the concentration of antinutritional compounds and improve the availability of their components, which interfere with the nutritional value of the products, by reducing protein digestibility and mineral absorption (Samtiya et al. 2020)
CONCLUSION
The matrices from discards of the fishing industry, supplemented with by-products from the dairy and brewing industries, provide a favorable environment for developing LAB. The use of waste from the food industry for animal feed suggests a potential advantage from the point of view of a circular economy. Silage production is an economical, safe, and versatile technology that is easy to implement, has minimal energy requirements, and is potentially applicable at artisanal and industrial levels, with the advantage of generating economic income from discards. Revaluing by-products through fermentation using lactic acid bacteria (LAB) with desirable biotechnological traits-such as pH reduction and the production of metabolites with antioxidants and antimicrobial properties-offers a cost-effective alternative to the use of preservatives and chemical antibiotics. Additionally, these food matrices are considered rich in essential minerals necessary for animal development. When combined with the proteolytic system of LAB, they promote protein degradation in silage into small peptides, which may enhance digestibility and nutrient absorption during passage through the animal's digestive tract. The high concentration of phosphorus and the absence of enzymatic induction of phytase activity during the fermentation demonstrated that most of the phytic acid was degraded during the brewing process. The stability and high concentration of divalent cations detected during the experience confirmed that they were not in chelated form with phytic acid. This study could be registered as the first time that waste from the dairy and brewing industry is used as an alternative carbon source to produce fermentation matrices and obtain fermented silage potentially applicable to animal feed. In future studies, a complete proximate analysis of the components present in the silage should be carried out, as well as the formulation and effect of the diet in vivo.
CONFLICT OF INTERESTS
The authors declare they have no conflict of interest.
REFERENCES
Apak R, Güçlü K, Özyürek M and Karademir SE (2004) Novel total antioxidant capacity index for dietary polyphenols and vitamins C and E, using their cupric ion reducing capability in the presence of neocuproine: CUPRAC method. Journal of Agricultural and Food Chemistry 52(26): 7970-7981. https://doi.org/10.1021/jf048741x
Baños A, Ariza JJ, Nuñez C, Gil-Martínez L, García-López JD et al (2019) Effects of Enterococcus faecalis UGRA10 and the enterocin AS-48 against the fish pathogen Lactococcus garvieae. Studies in vitro and in vivo. Food Microbiology 77: 69-77. https://doi.org/10.1016/j.fm.2018.08.002
Belda Palazón C (2022) La fermentación aplicada a la mejora de las propiedades funcionales de residuos y subproductos de alimentos de origen vegetal (Tesis de maestría). Universitat Politècnica de València. Valencia. España. 32p. https://riunet.upv.es/entities/publication/5f51e5b7-c342-4a70-a6e2-1f2a17c9da69
Bhagwat A and Annapure U (2019) In vitro assessment of metabolic profile of Enterococcus strains of human origin. Journal of Genetic Engineering and Biotechnology 17(11): 1-11. https://doi.org/10.1186/s43141-019-0009-0
Castillo García WE, Sánchez Suárez HA and Ochoa Mogollón GM (2019) Evaluación del ensilado de residuos de pescado y de cabeza de langostino fermentado con Lactobacillus fermentus aislado de cerdo. Revista de Investigaciones Veterinarias del Perú 30(4): 1456-1469. http://www.scielo.org.pe/scielo.php?script=sci_arttext&pid=S1609-91172019000400007
Cerdá E and Khalilova A (2016) Economía circular. Economía Industrial 401: 11-20. https://dialnet.unirioja.es/servlet/articulo?codigo=5771932
Chen L, Hui Y, Gao T, Shu G and Chen H (2021) Function and characterization of novel antioxidant peptides by fermentation with a wild Lactobacillus plantarum 60. LWT - Food Science and Technology 135. https://doi.org/10.1016/j.lwt.2020.110162
Chen R, Chen W, Chen H, Zhang G and Chen W (2018) Comparative evaluation of the antioxidant capacities, organic acids, and volatiles of papaya juices fermented by Lactobacillus acidophilus and Lactobacillus plantarum. Journal of Food Quality. https://doi.org/10.1155/2018/9490435
Church FC, Swaisgood HE, Porter DH and Catignani GL (1983) Spectrophotometric assay using o-phthaldialdehyde for determination of proteolysis in milk and isolated milk proteins. Journal of Dairy Science 66(6): 1219-1227. https://doi.org/10.3168/jds.S0022-0302(83)81926-2
Cortés-Sánchez ADJ, Jaramillo-Flores ME, Díaz-Ramírez M, Espinosa-Chaurand LD and Torres-Ochoa E (2024) Biopreservation and the safety of fish and fish products, the case of lactic acid bacteria: a basic perspective. Fishes 9: 303. https://doi.org/10.3390/fishes9080303
FAO - Food and Agriculture Organization of the Nations (2022a) El estado mundial de la pesca y la acuicultura 2022. Hacia la transformación azul. In FAO. https://doi.org/10.4060/cc0461es
FAO - Food and Agriculture Organization of the Nations (2022b) Dairy Market Review - Emerging trends and outlook. Rome. https://www.fao.org/3/cc3418en/cc3418en.pdf
Fernández Herrero AL, Fernández Compás A and Manca E (2015) Ensayo preliminar de obtención de ensilado biológico de anchoita (Engraulis anchoita), utilizando hez de malta de cebada (Hordeum vulgare L) como fuente de hidratos de carbono. Revista Electrónica de Veterinaria 16(3): 1-13. https://www.redalyc.org/pdf/636/63638740004.pdf
Gaur G and Gänzle MG (2023) Conversion of (poly)phenolic compounds in food fermentations by lactic acid bacteria: Novel insights into metabolic pathways and functional metabolites. Current Research in Food Science 6. https://doi.org/10.1016/j.crfs.2023.100448
Hsieh CC, Liu YH, Lin SP, Santoso SP, Jantama K et al (2024) Development of High-Glucosinolate-retaining lactic-acid-bacteria-co-fermented cabbage products. Fermentation 10(12). https://doi.org/10.3390/fermentation10120635
Jeitner TM (2014) Optimized ferrozine-based assay for dissolved iron. Analytical Biochemistry 454: 36-37. http://doi.org/10.1016/j.ab.2014.02.026
Jin X, Chen W, Chen H, Chen W and Zhong Q (2018) Comparative evaluation of the antioxidant capacities and organic acid and volatile contents of mango slurries fermented with six different probiotic microorganisms. Journal of Food Science 83(12): 3059-3068. https://doi.org/10.1111/1750-3841.14373
Kafesa A, Lutfi NNH and Wahyu C (2021) Chemometric analysis of serum magnesium calculations using Mg-Xylidyl Blue-I method based on molar absorptivity. Indonesian Journal of Medical Laboratory Science and Technology 3(1): 9-18.
Kieliszek M, Pobiega K, Piwowarek K and Kot AM (2021) Characteristics of the proteolytic enzymes produced by lactic acid bacteria. Molecules 26. https://doi.org/10.3390/molecules26071858
Leonarduzzi E, Rodrigues KA and Macchi GJ (2014) Proximate composition and energy density in relation to Argentine hake females (Merluccius hubbsi) morphometrics and condition indices. Fisheries Research 160: 33-40. http://doi.org/10.1016/j.fishres.2014.04.017
Liu K (2021) Trypsin inhibitor assay: expressing, calculating, and standardizing inhibitor activity in absolute amounts of Trypsin inhibited or trypsin inhibitors. JAOCS - Journal of the American Oil Chemists' Society 98(4): 355-373. https://doi.org/10.1002/aocs.12475
Liu K and Markakis P (1989) An improved colorimetric method for determining antitryptic activity in soybean products. Cereal Chemistry 66(5): 415-422. http://www.aaccnet.org/publications/cc/backissues/1989/Documents/66_415.pdf
Marguet ER, Ledesma P and Vallejo M (2013) Disponibilidad de fósforo soluble en ensilado experimental fermentado con una cepa de Lactococcus lactis subsp. lactis con alta actividad de fitasa. Revista de la Sociedad Venezolana de Microbiología 33: 116-121. https://ve.scielo.org/scielo.php?script=sci_arttext&pid=S1315-25562013000200006
Marguet E, Vallejo M, Schulman G, Ledesma P and Parada R (2017) Biosilo de residuos de merluza y harina de cebada fermentados con bacterias ácido lácticas seleccionadas. Biotecnología en el Sector Agropecuario y Agroindustrial 15(2): 112-120.
Marti-Quijal FJ, Remize F, Meca G, Ferrer E, Ruiz MJ and Barba FJ (2020) Fermentation in fish and by-products processing: an overview of current research and future prospects. Current Opinion in Food Science 31: 9-16. https://doi.org/10.1016/j.cofs.2019.08.001
Martínez Álvarez O (2011) Estado actual el aprovechamiento de subproductos de la industria pesquera mediante la obtención de productos de alto valor añadido. Alimentaria: Revista de Tecnología e Higiene de Los Alimentos 429: 71-80.
Mathias TRDS, Fernandes de Aguiar P, Batista de Almeida E Silva J et al (2016) Brewery waste reuse for protease production by lactic acid fermentation. food technology and biotechnology 55(2): 218-224. https://www.doi.org/10.17113/ftb.55.02.17.4378
Mathias TRDS, Moretzsohn de Mello PP and Camporese Servulo CS (2014) Solid wastes in brewing process: A review. Journal of Brewing and Distilling 5(1): 1-9. https://doi.org/10.5897/jbd2014.0043
Nuobariene L, Hansen AS, Jespersen L and Arneborg N (2011) Phytase-active yeasts from grain-based food and beer. Journal of Applied Microbiology 110(6): 1370-1380. https://doi.org/10.1111/j.1365-2672.2011.04988.x
Ozyurt G, Boga M, Uçar Y, Boga EK and Polat A (2017) Chemical, bioactive properties and in vitro digestibility of spray-dried fish silages: comparison of two discard fish (Equulites klunzingeri and Carassius gibelio) silages. Aquaculture Nutrition 24: 998-1005. https://doi.org/10.1111/anu.12636
Parada RB, Marguet E, Campos C and Vallejo M (2023) Improved antioxidant capacity of three Brassica vegetables by two-step controlled fermentation using isolated autochthone strains of the genus Leuconostoc spp. And Lactiplantibacillus spp. Food Chemistry: Molecular Sciences 6: 1-9. https://doi.org/10.1016/j.fochms.2023.100163
Peña García P, Querevalú Ortiz J, Ochoa Mogollón G and Sánchez Suárez H (2020) Ensilado biológico de residuos de langostino fermentado con bacterias ácido-lácticas: Uso como biofertilizante en cultivo de pasto y como alimento para cerdos de traspatio. Scientia Agropecuaria 11(4): 459-471.
Raeesi R, Shabanpour B and Pourashouri P (2021) Quality evaluation of produced silage and extracted oil from rainbow trout (Oncorhynchus mykiss) wastes using acidic and fermentation methods. Waste and Biomass Valorization 12(9): 4931-4942. https://doi.org/10.1007/s12649-020-01331-8
Ramirez Navas SJ (2012) Aprovechamiento industrial de lactosuero mediante procesos Fermentativos. Revista Especializada en Ingeniería de Procesos en Alimentos y Biomateriales 6: 69-83. https://doi.org/10.22490/25394088.1100
Ray Sarkar BC and Chauhan PS (1967) A new method for determining micro quantities of calcium in biological materials. Analytical Biochemistry 20: 155-166. https://doi.org/10.1016/0003-2697(67)90273-4
Samtiya M, Aluko RE and Dhewa T (2020) Plant food anti-nutritional factors and their reduction strategies: an overview. Food Production, Processing and Nutrition 2(6): 1-14. https://doi.org/10.1186/s43014-020-0020-5
Sakr EAE, Massoud MI and Ragaee S (2021) Food wastes as natural sources of lactic acid bacterial exopolysaccharides for the functional food industry: A review. International Journal of Biological Macromolecules 189: 232-241. https://doi.org/10.1016/j.ijbiomac.2021.08.135
Santacruz-Salas AP, Antunes MLP, Gomez-Herrera S, Velez Lozano JA and Donnini Mancini S (2023) Sostenibilidad en la industria cervecera: una revisión crítica de los residuos generados y su gestión. Biotecnología en el Sector Agropecuario y Agroindustrial 21(1). https://doi.org/10.18684/rbsaa.v21.n2.2023.2167
Shahidi F and Zhong Y (2015) Measurement of antioxidant activity. Journal of Functional Foods 18: 757-781. https://doi.org/10.1016/j.jff.2015.01.047
Sharma P, Sharma A and Lee HJ (2024) Antioxidant potential of exopolysaccharides from lactic acid bacteria: A comprehensive review. International Journal of Biological Macromolecules 281. https://doi.org/10.1016/j.ijbiomac.2024.135536
Sosa FM, Parada RB, Marguet ER and Vallejo M (2022) Utilization of agro-industrial byproducts for bacteriocin production using Enterococcus spp. strains isolated from patagonian marine invertebrates. Current Microbiology 79(16): 1-12. https://doi.org/10.1007/s00284-021-02712-5
Sosa FM, Parada RB, Sánchez-Cabrera MA, Marguet ER and Vallejo M (2023) Capacidad antioxidante de bacterias lácticas aisladas de peces e invertebrados marinos de la provincia de Chubut, Patagonia-Argentina. Revista de Ciencias Marinas y Costeras 15(1): 99-112. https://www.redalyc.org/articulo.oa?id=633775558006
Toppe J, Olsen R, Peñarubia O and James DG (2018) Producción y utilización del ensilado de pescado. Organizaciones de las Naciones Unidas para la Alimetación y la Agricultura 1-28. http://www.fao.org/3/i9606es/I9606ES.pdf
Wen J, Jiang W, Feng L, Kuang S, Jiang J, Tang L, Zhou X and Liu Y (2015) The influence of graded levels of available phosphorus on growth performance, muscle antioxidant and flesh quality of young grass carp (Ctenopharyngodon idella). Animal Nutrition 1(2): 77-84. https://doi.org/10.1016/j.aninu.2015.05.004
Yang J, Wu XB, Chen HL, Sun-waterhouse D, Zhong H and Cui C (2019) A value-added approach to improve the nutritional quality of soybean meal byproduct: Enhancing its antioxidant activity through fermentation by Bacillus amyloliquefaciens SWJS22. Food Chemistry 272: 396-403. https://doi.org/10.1016/j.foodchem.2018.08.037
Yoshida A, Ohta M, Kuwahara K, Cao MJ, Hara K and Osatomi K (2015) Purification and characterization of cathepsin B from the muscle of horse mackerel Trachurus japonicus. Marine Drugs 13: 6550-6565. https://doi.org/10.3390/md13116550
Zhang L, Liu C, Li D, Zhao Y, Zhang X, Zeng X, Yang Z and Li S (2013) Antioxidant activity of an exopolysaccharide isolated from Lactobacillus plantarum C88. International Journal of Biological Macromolecules 54(1): 270-275. https://doi.org/10.1016/j.ijbiomac.2012.12.037
